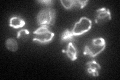
YHR037W
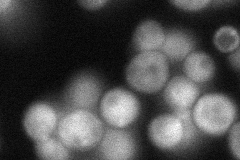
YHR037W
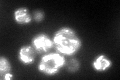
YHR037W
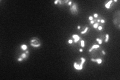
YHR037W

View description
Delta-1-pyrroline-5-carboxylate dehydrogenase, nuclear-encoded mitochondrial protein involved in utilization of proline as sole nitrogen source; deficiency of the human homolog causes HPII, an autosomal recessive inborn error of metabolism
Localization:
Intensity:
Fold change:
Significance:
-
C’ GFP library in SD
mitochondria54.11 -
N' NOP1pr-GFP in SD

mitochondria120.939 -
N' TEF2pr-mCherry in SD

mitochondria147.996 -
N' NATIVEpr-GFP in SD
cytosol,punctate60.8906 -
N' TEF2pr-VC and Cyto-VN in SD

#N/A0 -
C’ GFP library in SD+DTT
mitochondria88.951.64Yes -
C’ GFP library in SD+H2O2

mitochondria67.621.24No -
C’ GFP library in Starvation Media
punctateN/AN/AYes -
C’ GFP library on the background of Pup2-DaMP

mitochondria -
C’ GFP library on the background of CCT mutant

mitochondria62.17521.14894No
